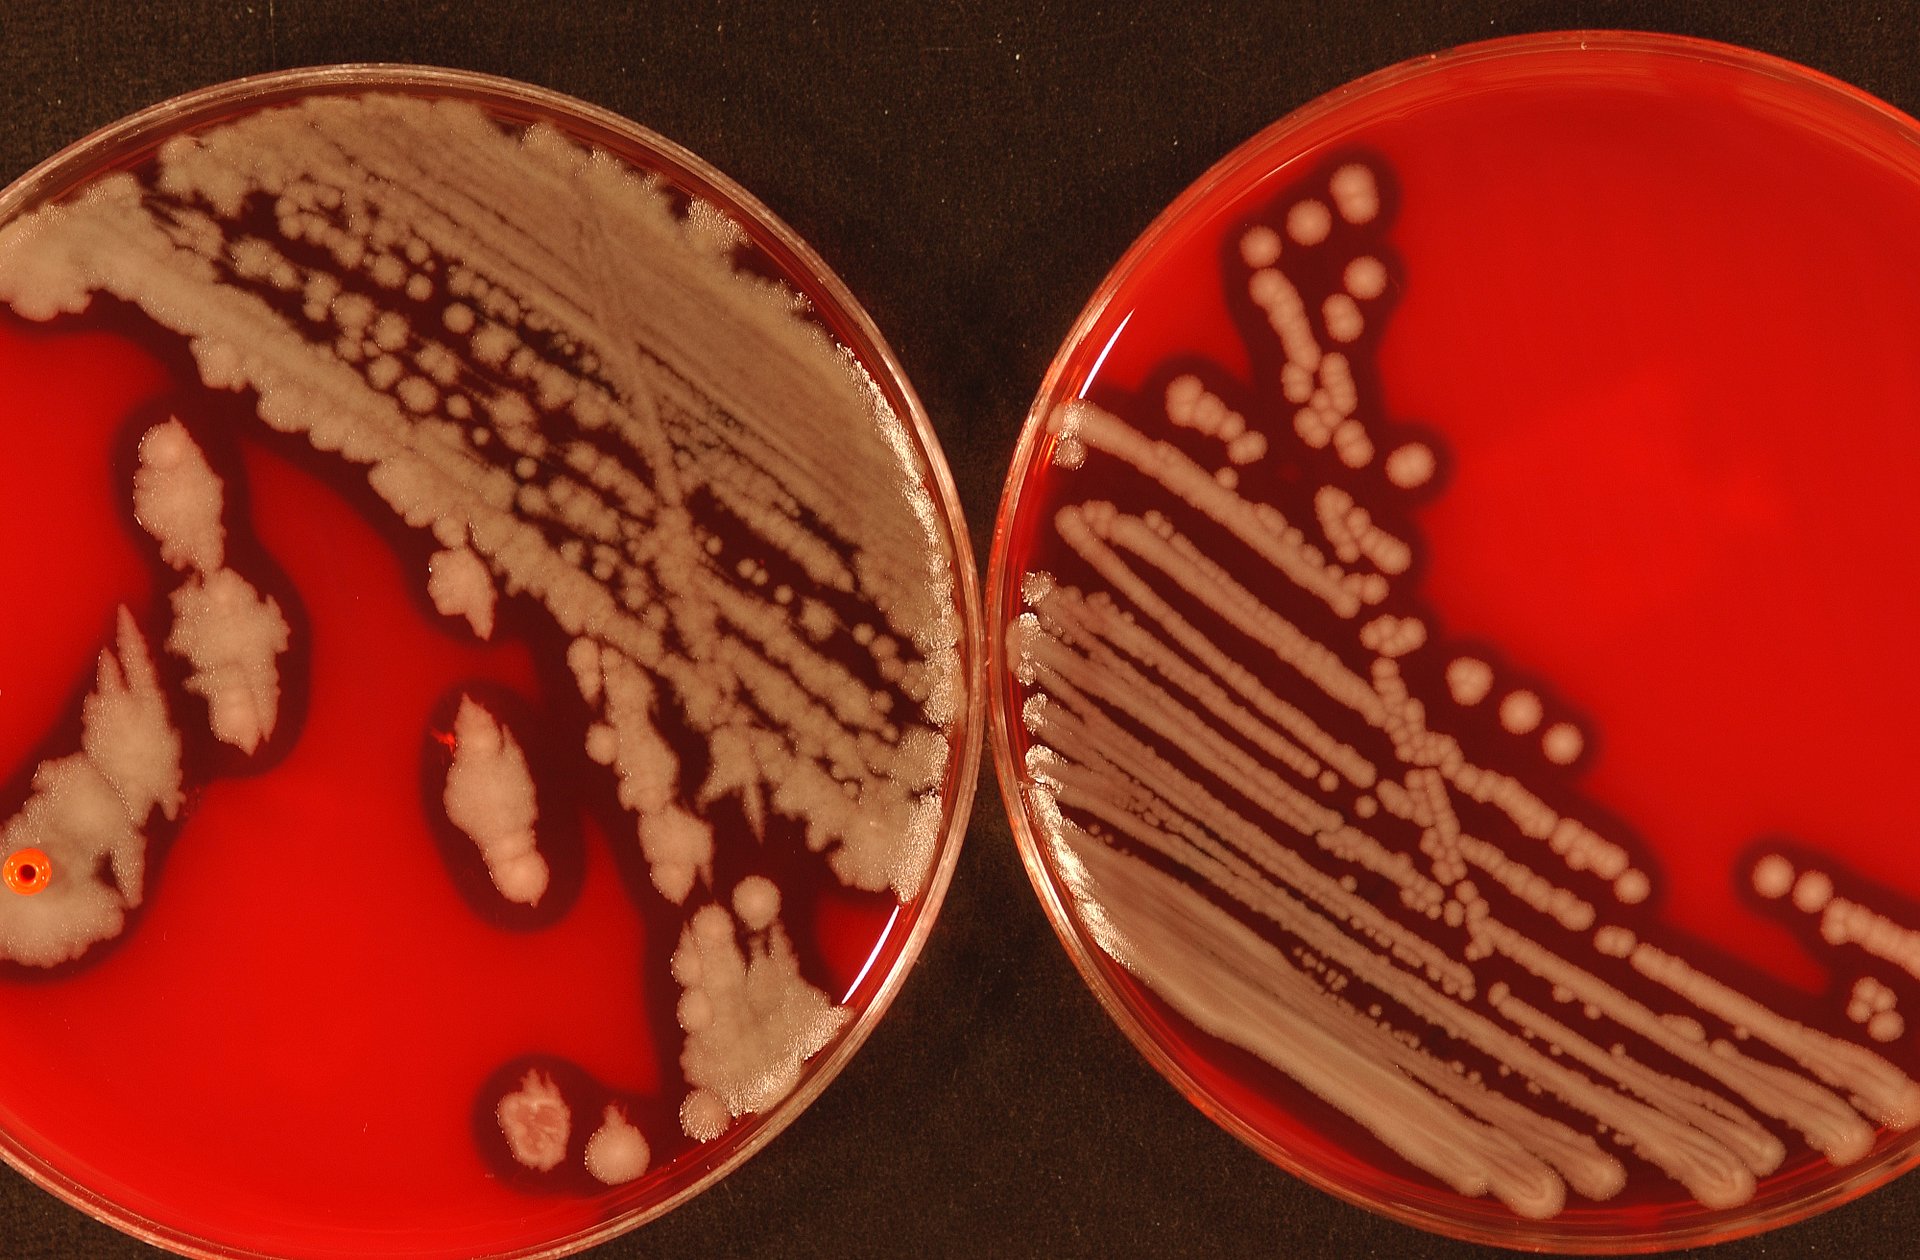
Typisches Wachstum von Bacillus cereus-Kolonien in Kulturschalen.

Lebensmittelvergiftungen: Neues Nachweisverfahren für Bakterientoxin
Ein Gift mit vielen Facetten
Europaweit steigt die Anzahl der durch Bacillus-Arten verursachten Lebensmittelvergiftungen. Die von B. cereus ausgelösten Infektionen sind zwar unangenehm, aber meist nicht lebensbedrohlich. Je nachdem, welches Toxin der Keim freisetzt, leiden die Patienten an Durchfall oder an Übelkeit und Erbrechen. Allerdings gibt es auch schwere, in sehr seltenen Fällen sogar tödliche Krankheitsverläufe.
Die Krankheitsform, die Übelkeit und Erbrechen hervorruft, bezeichnet man als emetisch. Dafür verantwortlich ist das Gift Cereulid. Wissenschaftlerinnen und Wissenschaftler der Technischen Universität München (TUM) und der Veterinärmedizinischen Universität Wien haben ein Nachweisverfahren für das Toxin entwickelt. Dabei konnten sie neben einem bereits bekannten Cereulid 18 weitere Varianten identifizieren.
Fertiggerichte erhöhen Risiko für Lebensmittelinfektionen
Erst kürzlich erkrankten in verschiedenen Kitas im Kreis Paderborn etwa 100 Kinder und Betreuer an einer B. cereus-Infektion: Es stellte sich heraus, dass sie Milchreis vom gleichen Caterer verzehrt hatten. Tatsächlich steigt mit dem Konsum vorgefertigter Gerichte das Risiko einer Lebensmittelvergiftung. Besonders vom B. cereus-Befall betroffen sind stärkehaltige Speisen wie Reis, Pasta und Kartoffeln.
„Dabei spielt oft fehlerhaftes Temperaturmanagement eine Rolle“, erläutert Prof. Thomas Hofmann vom Lehrstuhl für Lebensmittelchemie und sensorische Analytik. „Die Bakterien vermehren sich zum Beispiel in vorgekochten Lebensmitteln, die beim Aufwärmen nicht stark genug erhitzt bzw. davor nicht ausreichend gekühlt wurden.“
Außerdem kann B. cereus Sporen bilden, die auch bei starker Hitze überleben - und bei kühleren Temperaturen wieder funktionsfähige Bakterien hervorbringen. Häufig bilden diese dann Bakteriengifte, die wiederum hitzestabil sind – wie das Cereulid.
Toxin greift Zellmembran an
Das Toxin greift die Membran lebender Zellen an. Ihrem Aufbau nach ähneln Cereulide einer Zange, die ein Kalium-Ion umschließt. Die Kalium-Ionen ändern die elektrische Spannung an der Zellmembran, es kommt zur Schädigung der Membran bis hin zum Zelltod.
„Wie toxisch die einzelnen Cereulid-Formen wirken, hängt von ihrer chemischen Struktur ab: Je lipophiler, also fettliebender sie sind, umso besser können sie an die aus Fettsäuren bestehenden Membran andocken“, sagt Prof. Siegfried Scherer, der den Lehrstuhl für Mikrobielle Ökologie leitet.
Neues Nachweisverfahren wird erprobt
„Vor diesem Projekt gab es kein befriedigendes Nachweisverfahren für das Cereulid-Toxin in Lebensmitteln“, erklärt Hofmann „Mit unserem auf Massenspektrometrie basierenden Verfahren haben wir einen wichtigen Grundstein gelegt, das Bakteriengift zuverlässig nachzuweisen.“
Damit lässt sich künftig auch abschätzen, welches Risiko von kontaminierten Produkten ausgeht – und welche Bedeutung die verschiedenen Cereulid-Varianten dabei haben. Das neue Nachweisverfahren wird zur Zeit auf europäischer Ebene sowie zusammen mit der Food & Drug Administration (FDA) der USA evaluiert und auf den Einsatz vorbereitet.
Publikation:
Chemodiversity of cereulide, the emetic toxin of Bacillus cereus; Sandra Marxen, Timo D. Stark, Elrike Frenzel, Andrea Rütschle, Genia Lücking, Gabriel Pürstinger, Elena E. Pohl, Siegried Scherer, Monika Ehling-Schulz, Thomas Hofmann; Analytical and Bioanalytical Chemistry; DOI: 10.1007/s00216-015-8511-y
Kontakt:
Technische Universität München
Prof. Dr. Thomas Hofmann
Lehrstuhl für Lebensmittelchemie und molekulare Sensorik
Tel.: +49 8161 71-2902
thomas.hofmann@tum.de
www.molekulare-sensorik.de/startseite.html
Prof. Dr. Siegfried Scherer
Lehrstuhl für Mikrobielle Ökologie
Tel.: +49 8161 71-3516
siegfried.scherer@wzw.tum.de
micbio.wzw.tum.de/index.php
Technische Universität München
Corporate Communications Center
- Barbara Wankerl
- barbara.wankerl@tum.de
- presse@tum.de
- Teamwebsite